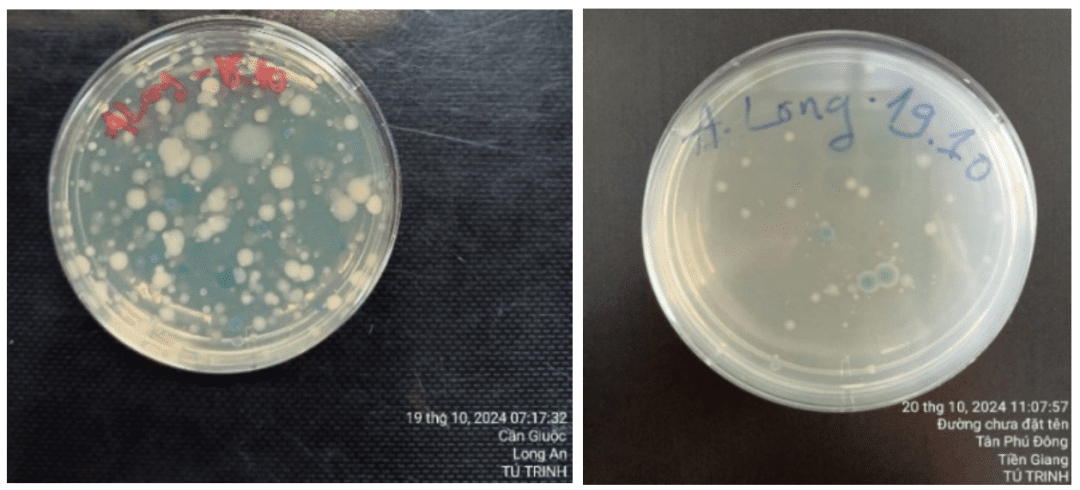

1. Bệnh do Vibrio
Bệnh do Vibrio spp. là một trong những thách thức lớn trong ngành tôm, gây thiệt hại nặng nề. Rất nhiều bệnh trên tôm có nguyên nhân từ Vibrio spp. như Hoại tử gan tụy cấp, TPD, phân trăng, đốm đen, phát sáng,…Trong đó, những loài gây bệnh thường gặp là: V.parahaemolyticus, V. harvey, V. alginolyticus; V. anguillarum; V. cholera; V. salmonicida, V. vulnificus…
Vì vậy, bệnh do Vibrio là vấn đề luôn được quan tâm.
2. Phát hiện Vibrio
Có một số phương pháp để phát hiện Vibrio, nhưng phương pháp kiểm tra phổ biến nhất là dùng đĩa môi trường chọn lọc TCBS và Chrom agar.

| Môi trường TCBS | Môi trường Chrom |
|
Khuẩn lạc vàng: V. anguillarum, V. alginolyticus, V. cholera, V. fluvialis, V. furnissii, V. tubiashii, V. mimicus, V. harveyi. Khuẩn lạc xanh: V. parahaemolyticus, V. proteolyticus, V. vulnificus. |
Khuẩn lạc tím: V. parahaemolyticus, Khuẩn lạc xanh ngọc: V. vulnificus Khuẩn lạc trắng đục: V. harveyi, V. alginolyticus, |
Vì Vibrio gây bệnh thường có trong hệ sinh thái ao nuôi tôm. Nó có trong nước và trong cơ thể tôm. Kiểm soát Vibrio ở mức bình thường là cực kỳ quan trọng nếu sự tăng trưởng Vibrio vượt quá phạm vi bình thường sẽ dẫn đến sự nhạy cảm với bệnh tật cao hơn. Có nhiều tiêu chuẩn ngưỡng tối đa về Vibrio trong các trang trại. Dưới đây là các ngưỡng tối đa phổ biến được các trang trại nuôi tôm áp dụng:
| Tham số | Ngưỡng tối đa |
| Tổng số Vibrio (TVC) trong nước ao | 103 – 104 CFU/ml |
| Tổng số Vibrio (TVC) trong ruột tôm | 105 CFU/g |
| Khuẩn lạc Vibrio | Khuẩn lạc xanh: 102 CFU/mL
Khuẩn lạc màu vàng: 103 CFU/mL |
| Tổng số Vibrio trên tổng số vi khuẩn | Dưới 10% |
Nguồn tham khảo: Aquaculture Asia Pacific
3. Kiểm soát Vibrio
Thiệt hại kinh tế lớn mà Vibrio gây ra đã dẫn đến sử dụng kháng sinh và hóa chất bừa bãi để kiểm soát. Tuy nhiên việc sử dụng không đúng cách, không những không kiểm soát được Vibrio mà còn dẫn đến các hậu quả đáng kể như tồn lưu hóa chất, kháng thuốc kháng sinh,…
Chính vì những khó khăn trong việc điều trị bệnh do Vibrio, nên giải pháp phòng ngừa vẫn là lựa chọn tối ưu:
– Lựa chọn giống sạch bệnh đã được chứng nhận từ các cơ sở uy tín.
– Lựa chọn mật độ nuôi phù hợp: Nuôi mật độ càng cao thì áp lực Vibrio càng cao.
– Giữ nồng độ Vibrio dưới ngưỡng tối đa (như bảng 1).
– Thực hiện tốt các biện pháp an toàn sinh học:
+ Phơi đáy và khử trùng ao, bón vôi trước khi bắt đầu vụ nuôi. Đối với ao lót bạt nên xịt khử trùng bạt.
+ Dụng cụ: rửa sạch, phơi khô và ngâm hoặc xịt sát trùng.
+ Nguồn nước khi cấp vào ao nuôi phải được lọc sạch và khử trùng.
+ Diệt vật chủ trung gian lây truyền mầm bệnh như cua còng, ốc, hến,…
+ Xi phong vệ sinh đáy ao thường xuyên để loại bỏ chất thải, lợn cợn ra khỏi ao.
+ Sử dụng men vi sinh cạnh tranh, đối kháng Vibrio.
+ Tăng cường sức đề kháng cho tôm nuôi.
+ Dùng kháng sinh: chỉ dùng để trị bệnh nhiễm khuẩn và dùng một số loại kháng sinh đã được Bộ NN&MT cho phép lưu hành.
4. Vitro – công cụ sát trùng phổ rộng, an toàn

Vitro là một giải pháp sát trùng an toàn, thân thiện với ao nuôi. Đây là công thức sát trùng dạng bột chứa nhiều thành phần có khả năng sát trùng phổ rộng tiêu diệt vi khuẩn, virus, nấm, ký sinh trùng. Ưu điểm là có thể dùng trực tiếp ao đang có tôm, kế cả tôm Post, tôm con mà không ảnh hưởng đến tảo và môi trường.
Sử dụng Vitro ngay từ đầu và định kỳ giúp giảm nồng độ Vibrio trong ao nuôi, đặc biệt khi sử dụng Vitro định kỳ 7 ngày/ lần giúp kiểm soát và duy trì nồng độ Vibrio ở ngưỡng an toàn – bảo vệ đàn tôm suốt vụ nuôi.
Vitro đã được ứng dụng rộng rãi và cho kết quả thành công trên nhiều farm nuôi thực tiển.
• Ví dụ như farm anh Long (Cần Giuộc, Long An): Sau khi dùng Vitro 1,3 ppm, mật độ Vibrio giảm từ 1.000 CFU/mL xuống chỉ còn 355 CFU/mL sau 24 giờ.
Kết quả farm anh Long trước và sau dùng Vitro
• Anh Đức (Thạnh Hóa, Long An): áp dụng liều 0,7 ppm, Vibrio giảm từ 2500 CFU/mL xuống 80 CFU/mL.

Kết quả farm anh Đức trước và sau dùng Vitro
• Chú Năm (Bình Chánh, TP. HCM): sử dụng Vitro định kỳ 7 ngày/lần, mật độ Vibrio luôn duy trì ngưỡng an toàn trong chu kỳ nuôi. Hiện tại tôm nuôi cho kết quả tốt 40 con/kg trong 67 ngày nuôi, và vẫn đang khỏe mạnh phát triển về size lớn hơn.

Kết quả dùng Vitro định kỳ của farm chú Năm
- Xuất khẩu tôm sang Hoa Kỳ và Trung Quốc bứt phá trong tháng 6, Trung Quốc tiếp tục dẫn dắt đà tăng trưởng
- Chính thức khánh thành Nhà máy Chế biến Tôm Minh Phú Khánh An, tạo việc làm cho hơn 5.000 lao động
- Hoa Kỳ: Điều chỉnh thuế chống bán phá giá đối với tôm Thái Lan
- Xuất khẩu thủy sản 5 tháng đầu năm 2026 đạt 4,66 tỷ USD: Ngành Tôm nỗ lực vượt “gió ngược”
- GrowMax được vinh danh “Thương hiệu xuất sắc châu Á” năm 2026
- Tôm hùm bông giống: Hoàn thiện quy trình ương nuôi, nâng tỷ lệ sống trên 90%
- Saudi Arabia chính thức dỡ bỏ lệnh cấm nhập khẩu tôm từ Indonesia
- Giá tôm nguyên liệu ngày 25/6: Dao động từ 82.000 – 103.000 đồng/kg
- Nguồn cung tôm của Malaysia vẫn ổn định bất chấp lệnh cấm nhập khẩu từ Thái Lan
- Ngọc Việt Group giảm giá sản phẩm vôi, khoáng để đồng hành cùng người nuôi thủy sản trước áp lực chi phí
Tin mới nhất
T4,01/07/2026
- Giá tôm ngày 1/7: Chênh lệch giữa các nhà máy, mức giá cao nhất lên tới 205.000 đồng/kg
- Xuất khẩu tôm sang Hoa Kỳ và Trung Quốc bứt phá trong tháng 6, Trung Quốc tiếp tục dẫn dắt đà tăng trưởng
- AHPND: Cảnh báo rủi ro lây qua không khí
- Giá tôm nguyên liệu ngày 30/6: Mức giá dao động trong khoảng từ 81.000 – 117.000 đồng/kg
- Truy xuất carbon: Thách thức mới và bước ngoặt phát triển bền vững của ngành tôm Việt Nam tại thị trường EU
- Chính thức khánh thành Nhà máy Chế biến Tôm Minh Phú Khánh An, tạo việc làm cho hơn 5.000 lao động
- Công bố danh mục thủ tục hành chính được sửa đổi, bổ sung và bãi bỏ trong lĩnh vực thủy sản và kiểm ngư
- Giá tôm nguyên liệu ngày 29/6: Thị trường nhìn chung ổn định, chỉ biến động nhẹ 1.000-3.000 đồng/kg ở một số cỡ tôm
- Hoa Kỳ: Điều chỉnh thuế chống bán phá giá đối với tôm Thái Lan
- Hà Tĩnh: Phát hiện 5 mẫu tôm dương tính với ký sinh trùng EHP
- Chính thức khánh thành Nhà máy Chế biến Tôm Minh Phú Khánh An, tạo việc làm cho hơn 5.000 lao động
- Saudi Arabia chính thức dỡ bỏ lệnh cấm nhập khẩu tôm từ Indonesia
- Nguồn cung tôm của Malaysia vẫn ổn định bất chấp lệnh cấm nhập khẩu từ Thái Lan
- Ngọc Việt Group giảm giá sản phẩm vôi, khoáng để đồng hành cùng người nuôi thủy sản trước áp lực chi phí
- Ghi nhận phản ánh về ô nhiễm môi trường, ảnh hưởng tới hiệu quả các vùng nuôi tôm
- An Giang tập huấn phòng bệnh chủ động cho người nuôi tôm nước lợ tại xã An Minh
- Vĩnh Long: Giá tôm thẻ chân trắng giảm sâu trong 3 tháng liên tiếp
- Âm thanh dưới đáy ao: Dữ liệu mới trong nuôi tôm hiện đại
- Giải pháp toàn diện kiểm soát mầm bệnh, phát triển nuôi trồng thủy sản bền vững
- Trường Đại học Nha Trang đăng cai Hội nghị Nuôi trồng Thủy sản châu Á – Thái Bình Dương 2027
- Giá bao bì nhựa gia tăng, tạo “gánh nặng kép” cho doanh nghiệp thủy sản
- Vi tảo: Nguyên liệu giàu protein và hợp chất hoạt tính sinh học
- Học viện Nông nghiệp Việt Nam: Giải mã nguyên nhân gây chết hàng loạt cá Nâu nuôi tại Huế
- Bình Định tăng cường quản lý hoạt động khai thác, bảo vệ nguồn lợi thủy sản
- Thủy sản Việt Nam tìm cách thoát ‘bẫy phụ thuộc’
- Xuất khẩu tôm: Cần xây dựng thương hiệu gắn với chất lượng
Các ấn phẩm đã xuất bản
- Giá tôm ngày 1/7: Chênh lệch giữa các nhà máy, mức giá cao nhất lên tới 205.000 đồng/kg
- Xuất khẩu tôm sang Hoa Kỳ và Trung Quốc bứt phá trong tháng 6, Trung Quốc tiếp tục dẫn dắt đà tăng trưởng
- Giá tôm nguyên liệu ngày 30/6: Mức giá dao động trong khoảng từ 81.000 – 117.000 đồng/kg
- Truy xuất carbon: Thách thức mới và bước ngoặt phát triển bền vững của ngành tôm Việt Nam tại thị trường EU
- Giá tôm nguyên liệu ngày 29/6: Thị trường nhìn chung ổn định, chỉ biến động nhẹ 1.000-3.000 đồng/kg ở một số cỡ tôm
- Công bố danh mục thủ tục hành chính được sửa đổi, bổ sung và bãi bỏ trong lĩnh vực thủy sản và kiểm ngư
- Xuất khẩu thủy sản 5 tháng đầu năm 2026 đạt 4,66 tỷ USD: Ngành Tôm nỗ lực vượt “gió ngược”
- Hà Tĩnh: Phát hiện 5 mẫu tôm dương tính với ký sinh trùng EHP
- Chiến lược ngành tôm: Thích ứng với thách thức khí hậu và dịch bệnh
- GrowMax được vinh danh “Thương hiệu xuất sắc châu Á” năm 2026
- An toàn sinh học: Giải pháp then chốt cho bài toán dịch bệnh thủy sản
- Sử dụng sóng siêu âm để tính sinh khối ao nuôi tôm
- Máy sưởi ngâm: Cách mạng hóa nghề nuôi tôm ở Việt Nam
- Waterco: Giải pháp thiết bị hàng đầu trong nuôi trồng thủy sản
- GROSHIELD: “Trợ thủ đắc lực” giúp tôm đề kháng vững vàng hàng ngày, sẵn sàng về đích
- Năm mới, nỗi lo cũ: “Làm sao để tăng cường đề kháng cho tôm?”
- Vi sinh: Giải pháp mục tiêu toàn diện
- Grobest Việt Nam: Tiên phong ra mắt sản phẩm thức ăn chức năng hàng ngày Groshield, nâng cao tối đa sức đề kháng, hướng đến những vụ tôm về đích thành công trong năm tới
- Solagron Vietnam: Nhà sản xuất vi tảo công nghiệp đầu tiên mang dấu ấn Việt Nam
- Giải pháp giảm phát thải trong nuôi trồng thủy sản từ bột cá thủy phân








































